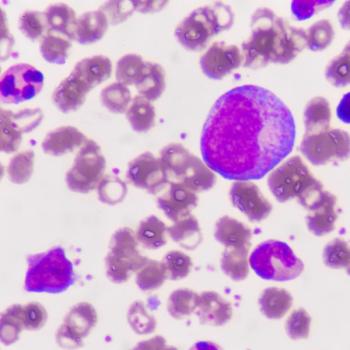

News


Read nursing considerations for treating patients with mantle cell lymphoma using lisocabtagene maraleucel.

Subcutaneous pembrolizumab has been approved across all indications, cutting chair and administration times with a median injection time of 2 minutes.

Zidesamtinib, a brain-penetrant, TRK-sparing ROS1 TKI, showed activity and manageable safety in pretreated patients with advanced ROS1+ NSCLC.

Courtney Moore, APRN, FNP-C, OCN, discusses how patient comorbidities and adverse effect profiles guide CDK4/6 inhibitor choice in the first-line setting.

Michelle Kirschner, MSN, RN, ACNP, APRN-BC, discusses precision supportive care and tailored survivorship strategies in an ONN interview.

Mosunetuzumab plus polatuzumab vedotin increased PFS and response rates vs R-GemOx in transplant-ineligible large B-cell lymphoma.

Explore stories of oncology nurses who forge connections with patients, transforming challenges into triumphs in cancer care.

When treating patients with bladder cancer using gemcitabine intravesical system, regular AE monitoring is necessary, said Gary Steinberg, MD.

How best can senior staff and leadership support nurses new to the field of oncology?

At SOHO 2025, Lorenzo Falchi, MD, highlighted the critical role of nurses in monitoring and educating patients on toxicities from novel lymphoma therapies.

FLAURA2 data show osimertinib plus chemotherapy significantly improves overall survival vs osimertinib alone in frontline EGFR+ advanced NSCLC.

Michelle Kirschner, MSN, RN, ACNP, APRN-BC, discusses how precision supportive care tailors interventions to patient needs.

Lutetium Lu 177 dotatate was linked with partial responses in patients with metastatic bronchopulmonary neuroendocrine tumors, per real-world data.

Benjamin Besse, MD, PhD, shares AE management strategies for amivantamab/lazertinib in EGFR-positive NSCLC following CHRYSALIS-2 results.

Read an advanced practice nurse's tips for treating patients with endometrial cancer with durvalumab.

Relacorilant’s new drug application for platinum-resistant ovarian cancer has been accepted by the FDA.

Tepotinib was associated with frequent but manageable adverse events in MET exon 14–positive NSCLC, with peripheral edema most common.

Formerly known as TAR-200, gemcitabine intravesical system has received the FDA’s approval for use in patients with BCG-unresponsive NMIBC.

Ghayas C. Issa, MD, MS, discusses key adverse events of menin inhibitors in NPM1-mutated and KMT2Ar AML.

Adding ivonescimab to chemotherapy improved PFS for patients with EGFR-mutated non–small cell lung cancer after treatment with a third-generation TKI.

Expert Kelsey Martin shares nursing insights on balancing glucose control and GI side effects when caring for patients on PI3K and AKT inhibitors.

New AQUILA data show PFS improvement in patients with smoldering multiple myeloma who were treated with subcutaneous daratumumab vs active monitoring.

Mortality, progression, and venous thromboembolism were among outcomes improved for patients with polycythemia vera taking a GLP-1a.

Familiarity with each component of antibody-drug conjugates helps nurses and APPs deliver proactive adverse event management to patients with cancer.

Patients with intermediate- or high-risk MDS experienced a higher modified overall response rate with the venetoclax/azacitidine vs placebo/azacitidine.

Lisa Hwa Christenson, DNP, CNP, FAPO, shares best practices for monitoring CRS and ICANS with BCMA bispecific antibodies in community oncology.

Biology-guided radiotherapy involves teamwork across multiple specialists, according to Samantha Bianzon, BSN, RN.

Understanding which patients may benefit from CLDN6-targeting immunotherapy and recognizing potential adverse effects is essential for oncology nurses.